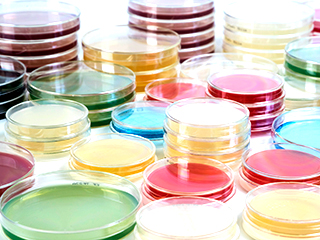
南越ケミカルの微生物用培地

top of page

医薬品・化粧品製造に関連する気になるカタログにチェックを入れると、まとめてダウンロードいただけます。
微生物の検出とは?課題と対策・製品を解説

目的・課題で絞り込む
カテゴリで絞り込む
医薬品・化粧品製造 |
医薬品原料 |
バイオ医薬 |
医薬品DX |
研究・開発 |
再生医療 |
その他医薬品・化粧品製造 |

計測・検査・品質管理における微生物の検出とは?
医薬品・化粧品製造業界において、製品の安全性と品質を保証するために、製造工程や最終製品に含まれる微生物を検出し、その数を管理すること。これにより、製品の汚染や劣化を防ぎ、消費者の健康を守ることを目的とする。
各社の製品
絞り込み条件:
▼チェックした製品のカタログをダウンロード
一度にダウンロードできるカタログは20件までです。
品質試験受託サービス
南越ケミカルの微生物用培地
製造環境モニタリング用 γ線照射済み生培地
『BD BBL(TM) γ線照射済み生培地シリーズ』は、
培地製造後、速やかにγ線照射施設に保冷輸送し、培地分注開始から所定の時間内にγ線照射を行っています。
第18改正日本薬局方の微生物限度試験、無菌医薬品製造区域の微生物評価試験法、保存効力試験法における、培地性能試験管理菌株すべてについて、ロットごとに回収率を明記した成績証明書を発行しておりますので、安心してご使用いただけます。
【特長】
■ 福島工場で製造、安定供給を実現
■ 4℃~25℃保管可能
冷蔵庫内または、常温の無菌製造区域内でも保管可能です。
■ シャーレのロックが簡単
ロック式シャーレにより、落としてもフタが脱落せず、サンプル採取後の汚染を防ぎます。
■ 側面印字
コロニーの観察・計測の妨げになるロット番号等の情報をシャーレ側面に印字。
■ 幅広い中和能、SCDLPプラス
機器や器具表面および医薬品製造区域内などに残留した殺菌剤や消毒剤による偽陰性リスクを低減させるため、4つの中和剤を含有。
※技術資料は一部データを割愛 しておりますので、製品性能の詳細に関してはお気軽にお問い合わせください。